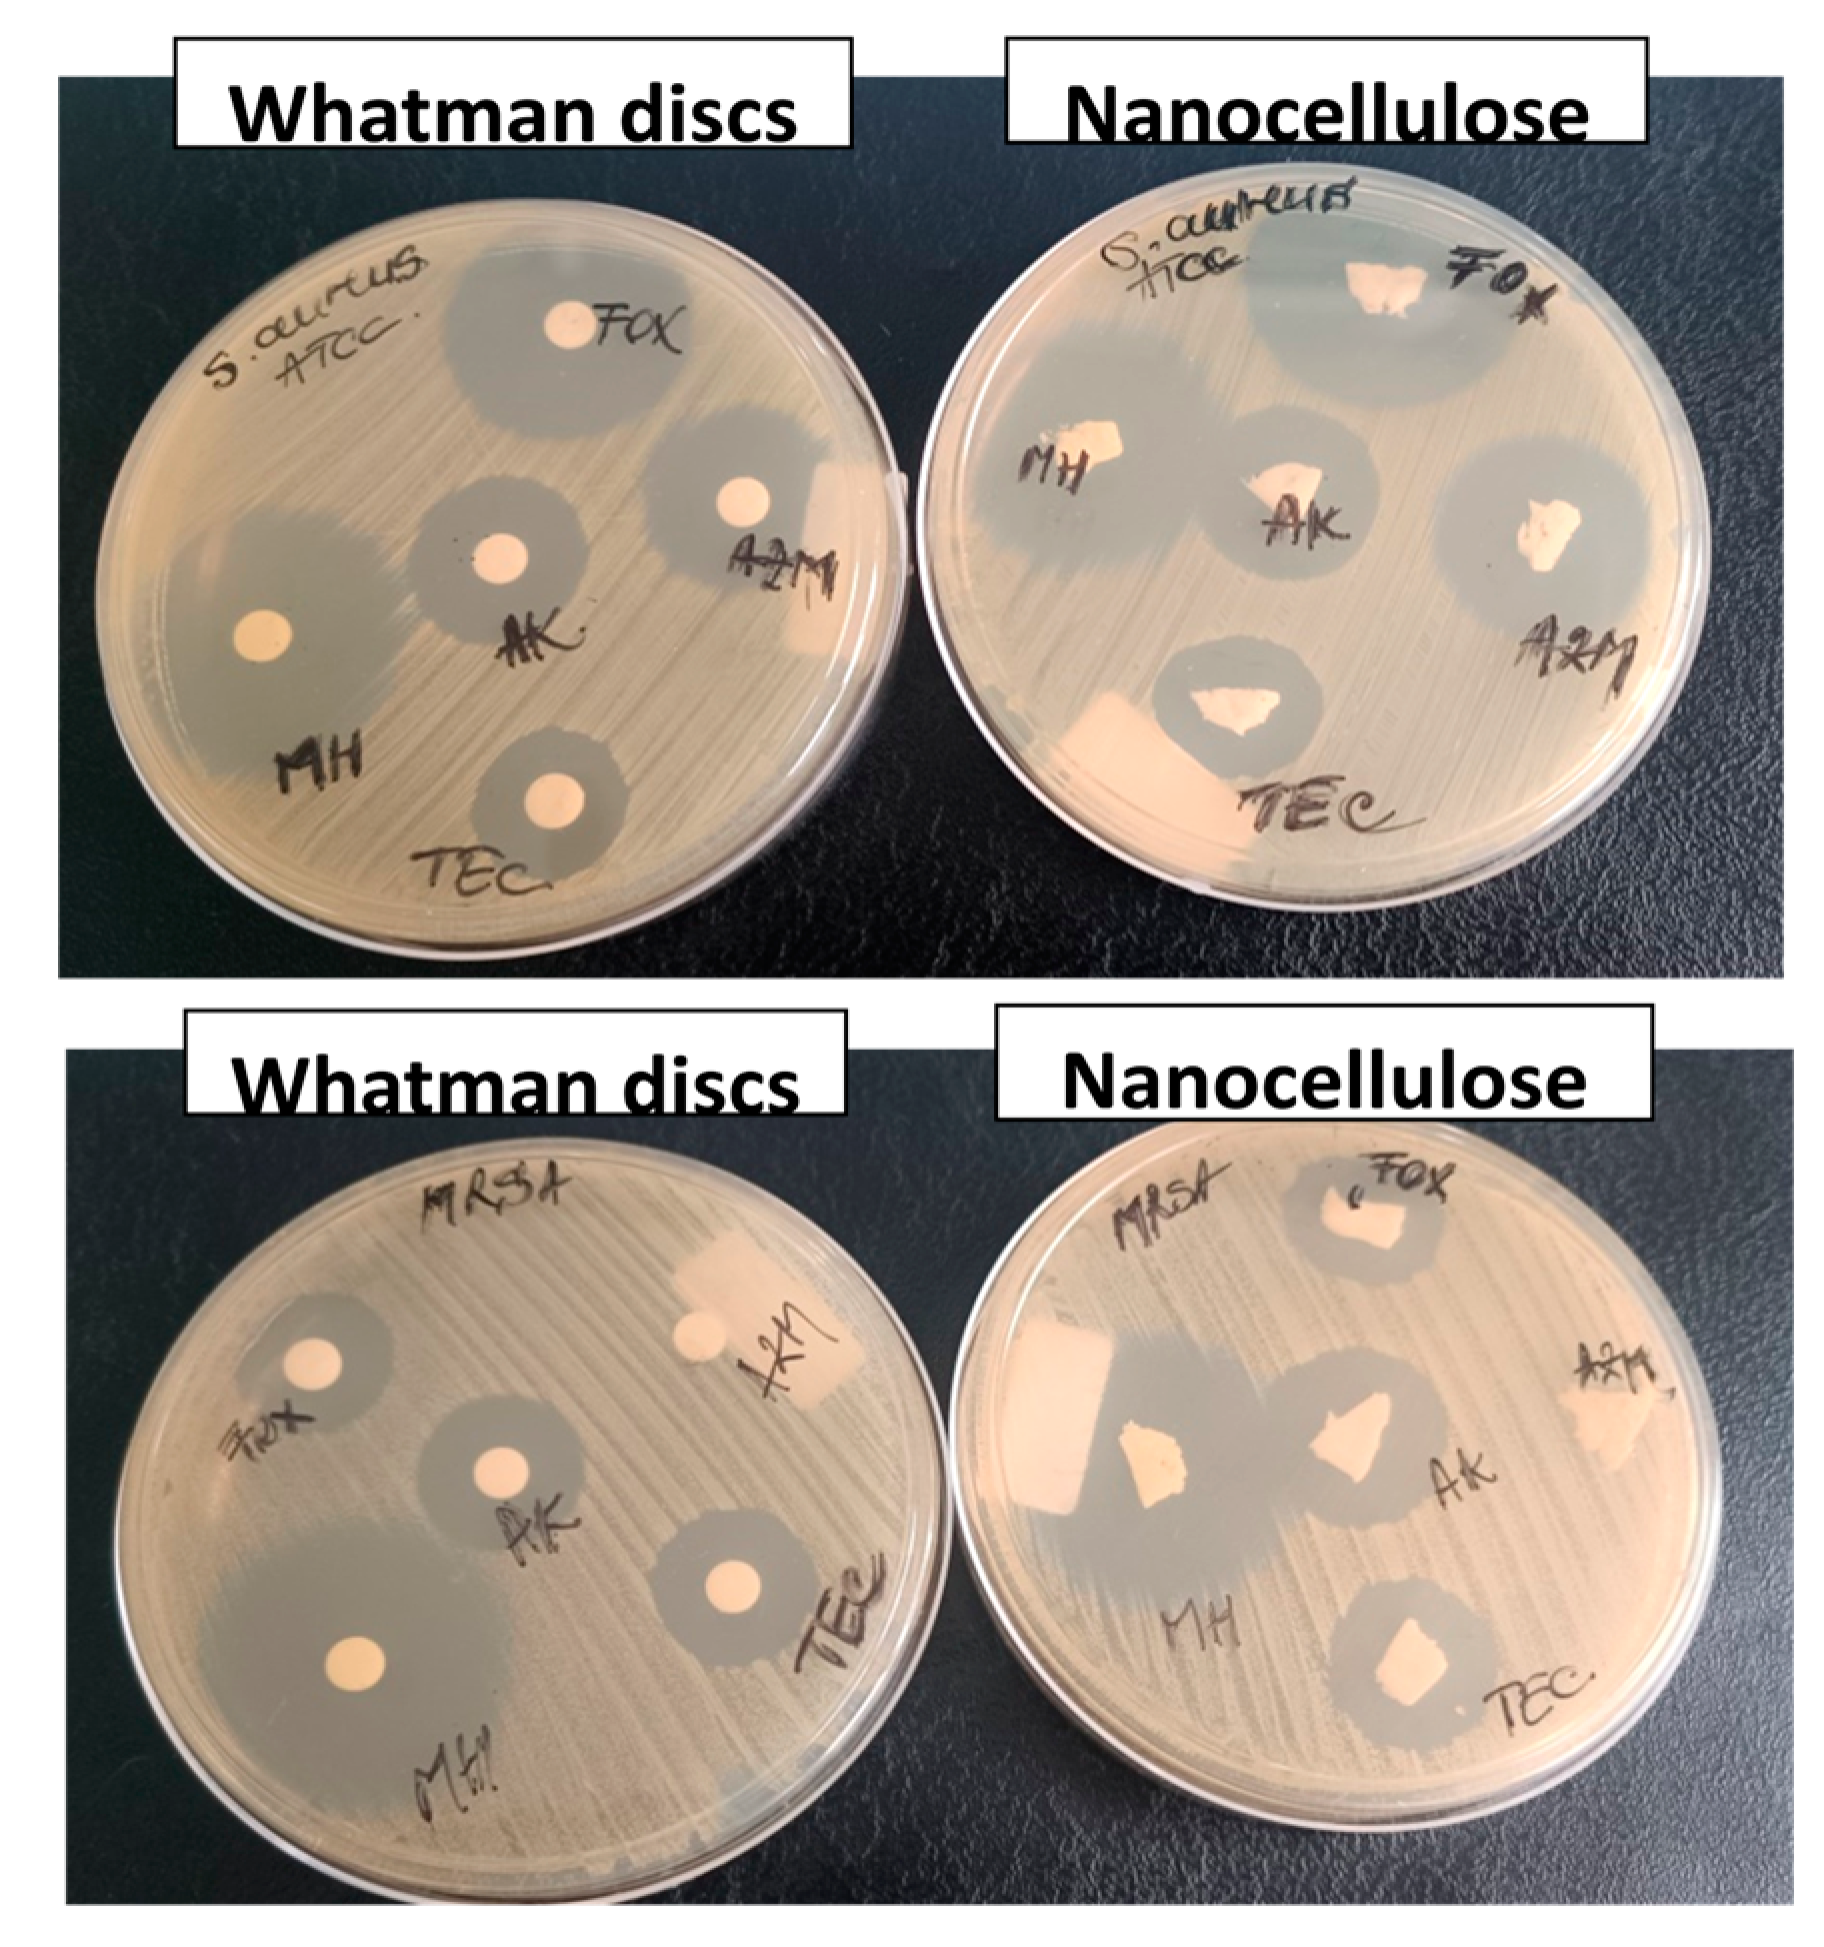

Plant-Derived Nanocellulose with Antibacterial Activity for Wound Healing Dressing
Abstract
:1. Introduction
2. Materials and Methods
2.1. Materials
2.2. Preparation of Nanocellulose Sponges
2.3. Characterization
2.3.1. Fourier-Transform Infrared Spectroscopy (FTIR) Spectroscopy
2.3.2. Thermogravimetric Analysis (TGA)
2.3.3. Scanning Electron Microscopy (SEM)
2.3.4. Dynamic Mechanical Analysis (DMA)
2.3.5. Antibacterial Test
3. Results and Discussion
3.1. Fourier-Transform Infrared Spectroscopy (FTIR) Spectroscopy
3.2. Scanning Electron Microscopy (SEM)
3.3. Thermogravimetric Analysis (TGA)
3.4. Dynamic Mechanical Analysis (DMA)
3.5. Antibacterial Efficacy Assessment
4. Conclusions
Author Contributions
Funding
Institutional Review Board Statement
Informed Consent Statement
Data Availability Statement
Acknowledgments
Conflicts of Interest
References
- Hajiali, F.; Jin, T.; Yang, G.; Santos, M.; Lam, E.; Moores, A. Mechanochemical Transformations of Biomass into Functional Materials. ChemSusChem 2022, 15, e202102535. [Google Scholar] [CrossRef]
- Panaitescu, D.M.; Frone, A.N.; Chiulan, I. Nanostructured biocomposites from aliphatic polyesters and bacterial cellulose. Ind. Crop. Prod. 2016, 93, 251–266. [Google Scholar] [CrossRef]
- Meng, S.; Wu, H.; Xiao, D.; Lan, S.; Dong, A. Recent advances in bacterial cellulose-based antibacterial composites for infected wound therapy. Carbohydr. Polym. 2023, 316, 121082. [Google Scholar] [CrossRef] [PubMed]
- Usurelu, C.D.; Badila, S.; Frone, A.N.; Panaitescu, D.M. Poly(3-hydroxybutyrate) nanocomposites with cellulose nanocrystals. Polymers 2022, 14, 1974. [Google Scholar] [CrossRef] [PubMed]
- Wang, J.; Han, X.; Zhang, C.; Liu, K.; Duan, G. Source of Nanocellulose and Its Application in Nanocomposite Packaging Material: A Review. Nanomaterials 2022, 12, 3158. [Google Scholar] [CrossRef] [PubMed]
- Shen, R.; Xue, S.; Xu, Y.; Liu, Q.; Feng, Z.; Ren, H.; Zhai, H.; Kong, F. Research Progress and Development Demand of Nanocellulose Reinforced Polymer Composites. Polymers 2020, 12, 2113. [Google Scholar] [CrossRef]
- Lin, N.; Dufresne, A. Nanocellulose in biomedicine: Current status and future prospect. Eur. Polym. J. 2014, 59, 302–325. [Google Scholar] [CrossRef]
- Fernandes, D.A. Review on the applications of nanoemulsions in cancer theranostics. J. Mater. Res. 2022, 37, 1953–1977. [Google Scholar] [CrossRef]
- Markets and Markets (M&M). Wound Dressings Market Trends & Growth Drivers. Available online: https://www.marketsandmarkets.com/Market-Reports/wound-dressings-market-123903496.html?gclid=CjwKCAjw4P6oBhBsEiwAKYVkq-GoITxAz6oqzh8coO7s_njWW8gU9doon59KDYBXGfWk1n7E9wyzlBoCT2YQAvD_BwE (accessed on 2 October 2023).
- Singla, R.; Soni, S.; Patial, V.; Kulurkar, P.M.; Kumari, A.; Padwad, Y.S.; Yadav, S.K. Cytocompatible Anti-microbial Dressings of Syzygiumcumini Cellulose Nanocrystals Decorated with Silver Nanoparticles Accelerate Acute and Diabetic Wound Healing. Sci. Rep. 2017, 7, 10457. [Google Scholar] [CrossRef]
- Li, T.; Chen, C.; Brozena, A.H.; Zhu, J.Y.; Xu, L.; Driemeier, C.; Dai, J.; Rojas, O.J.; Isogai, A.; Wågberg, L.; et al. Developing fibrillated cellulose as a sustainable technological material. Nature 2021, 590, 47–56. [Google Scholar] [CrossRef]
- Kupnik, K.; Primožič, M.; Kokol, V.; Leitgeb, M. Nanocellulose in Drug Delivery and Antimicrobially Active Materials. Polymers 2020, 12, 2825. [Google Scholar] [CrossRef]
- Zheng, L.; Li, S.; Luo, J.; Wang, X. Latest Advances on Bacterial Cellulose-Based Antibacterial Materials as Wound Dressings. Front. Bioeng. Biotechnol. 2020, 8, 593768. [Google Scholar] [CrossRef]
- Nosrati, H.; Heydari, M.; Tootiaei, Z.; Ganjbar, S.; Khodaei, M. Delivery of antibacterial agents for wound healing applications using polysaccharide-based scaffolds. J. Drug Deliv. Sci. Technol. 2023, 84, 104516. [Google Scholar] [CrossRef]
- World Health Organization (WHO). Diabetes. Available online: https://www.who.int/health-topics/diabetes#tab=tab_1 (accessed on 2 October 2023).
- Marquele-Oliveira, F.; Da Silva Barud, H.; Torres, E.C.; Machado, R.T.A.; Caetano, G.F.; Leite, M.N.; Frade, M.A.C.; Ribeiro, S.J.; Berretta, A.A. Development, characterization and pre-clinical trials of an innovative wound healing dressing based on propolis (EPP-AF®)-containing self-microemulsifying formulation incorporated in biocellulose membranes. Int. J. Biol. Macromol. 2019, 136, 570–578. [Google Scholar] [CrossRef]
- Oprică, G.M.; Panaitescu, D.M.; Usurelu, C.D.; Vlăsceanu, G.M.; Stanescu, P.O.; Lixandru, B.E.; Vasile, V.; Gabor, A.R.; Nicolae, C.-A.; Ghiurea, M.; et al. Nanocellulose Sponges Containing Antibacterial Basil Extract. Int. J. Mol. Sci. 2023, 24, 11871. [Google Scholar] [CrossRef]
- Huang, S.; Zhang, C.-P.; Wang, K.; Li, G.Q.; Hu, F.-L. Recent Advances in the Chemical Composition of Propolis. Molecules 2014, 19, 19610–19632. [Google Scholar] [CrossRef]
- Salama, A.; El-Sakhawy, M. Polysaccharides/propolis composite as promising materials with biomedical and packaging applications: A review. Biomass Conv. Bioref. 2022. Online first article. [Google Scholar] [CrossRef]
- Isopescu, R.D.; Spulber, R.; Josceanu, A.M.; Mihaiescu, D.E.; Popa, O. Romanian bee pollen classification and property modelling. J. Apic. Res. 2020, 59, 443–451. [Google Scholar] [CrossRef]
- Oryan, A.; Alemzadeh, E.; Moshiri, A. Potential role of propolis in wound healing: Biological properties and therapeutic activities. Biomed. Pharmacother. 2018, 98, 469–483. [Google Scholar] [CrossRef] [PubMed]
- Shaker, S.A.; Alshufta, S.M.; Gowayed, M.A.; El-Salamouni, N.S.; Bassam, S.M.; Megahed, M.A.; El-Tahan, R.A. Propolis-loaded nanostructured lipid carriers halt breast cancer progression through miRNA-223 related pathways: An in-vitro/in-vivo experiment. Sci. Rep. 2023, 13, 15752. [Google Scholar] [CrossRef] [PubMed]
- Ramadoss, P.; ·Dakshanamoorthy, A.; Basha, S.H. Drug eluting bioresorbable cellulose acetate/PEO/HPMC composite with propolis extracts for suturing application. J. Mater. Sci. Surf. Eng. 2021, 8, 1010–1020. [Google Scholar] [CrossRef] [PubMed]
- Saleh, S.; Salama, A.; Ali, A.M.; Saleh, A.K.; AbdElhady, B.; Tolba, E. Egyptian propolis extract for functionalization of cellulose nanofiber/poly(vinyl alcohol) porous hydrogel along with characterization and biological applications. Sci. Rep. 2023, 13, 7739. [Google Scholar] [CrossRef] [PubMed]
- Voss, G.T.; Gularte, M.S.; Vogt, A.G.; Giongo, J.L.; Vaucher, R.A.; Echenique, J.V.; Soares, M.P.; Luchese, C.; Wilhelm, E.A.; Fajardo, A.R. Polysaccharide-based film loaded with vitamin C and propolis: A promising device to accelerate diabetic wound healing. Int. J. Pharm. 2018, 552, 340–351. [Google Scholar] [CrossRef] [PubMed]
- Mocanu, A.; Isopencu, G.; Busuioc, C.; Popa, O.; Dietrich, P. Bacterial cellulose films with ZnO nanoparticles and propolis extracts: Synergistic antimicrobial effect. Sci. Rep. 2019, 9, 17687. [Google Scholar] [CrossRef] [PubMed]
- Gonçalves, I.S.; Lima, L.R.; Berretta, A.A.; Amorim, N.A.; Pratavieira, S.; Corrêa, T.Q.; Nogueira, F.A.R.; Barud, H.S. Antimicrobial Formulation of a Bacterial Nanocellulose/Propolis-Containing Photosensitizer for Biomedical Applications. Polymers 2023, 15, 987. [Google Scholar] [CrossRef]
- Picolotto, A.; Pergher, D.; Pereira, G.P.; Machado, K.G.; da Silva Barud, H.; Roesch-Ely, M.; Gonzalez, M.H.; Tasso, L.; Figueiredo, J.G.; Moura, S. Bacterial cellulose membrane associated with red propolis as phytomodulator: Improved healing effects in experimental models of diabetes mellitus. Biomed. Pharmacother. 2019, 112, 108640. [Google Scholar] [CrossRef]
- De Amorim, J.D.P.; de Souza, K.C.; Duarte, C.R.; da Silva Duarte, I.; de Assis Sales Ribeiro, F.; Santos Silva, G.; Albuquerque de Farias, P.M.; Stingl, A.; Santana Costa, A.F.; Vinhas, G.M.; et al. Plant and bacterial nanocellulose: Production, properties and applications in medicine, food, cosmetics, electronics and engineering. A review. Environ. Chem. Lett. 2020, 18, 851–869. [Google Scholar] [CrossRef]
- Amorim, J.D.P.; Nascimento, H.A.; Silva Junior, C.J.G.; Medeiros, A.D.M.; Silva, I.D.L.; Costa, A.F.S.; Vinhas, G.M.; Sarubbo, L.A. Obtainment of bacterial cellulose with added propolis extract for cosmetic applications. Polym. Eng. Sci. 2022, 62, 565. [Google Scholar] [CrossRef]
- Barhoum, A.; Rastogi, V.K.; Mahur, B.K.; Rastogi, A.; Abdel-Haleem, F.M.; Samyn, P. Nanocelluloses as new generation materials: Natural resources, structure-related properties, engineering nanostructures, and technical challenges. Mater. Today Chem. 2022, 26, 101247. [Google Scholar] [CrossRef]
- Matuschek, E.; Brown, D.; Kahlmeter, G. Development of the EUCAST disk diffusion antimicrobial susceptibility testing method and its implementation in routine microbiology laboratories. Clin. Microbiol. Infect. 2014, 20, O255–O266. [Google Scholar] [CrossRef]
- CLSI. Performance Standards for Antimicrobial Susceptibility Testing, 26th ed.; Supplement M100S; Clinical and Laboratory Standard Institute (CLSI): Wayne, PA, USA, 2016. [Google Scholar]
- Li, Q.; Renneckar, S. Supramolecular structure characterization of molecularly thin cellulose I nanoparticles. Biomacromolecules 2011, 12, 650–659. [Google Scholar] [CrossRef]
- Carrillo, I.; Mendonça, R.T.; Ago, M.; Rojas, O.J. Comparative study of cellulosic components isolated from different Eucalyptus species. Cellulose 2018, 25, 1011–1029. [Google Scholar] [CrossRef]
- Aguayo, M.G.; Fernández Pérez, A.; Reyes, G.; Oviedo, C.; Gacitúa, W.; Gonzalez, R.; Uyarte, O. Isolation and characterization of cellulose nanocrystals from rejected fibers originated in the kraft pulping process. Polymers 2018, 10, 1145. [Google Scholar] [CrossRef]
- Lin, D.; Li, Y.; Huang, Y.; Qin, W.; Loy, D.A.; Chen, H.; Zhang, Q.; Wu, Z. Properties of polyvinyl alcohol films reinforced by citric acid modified cellulose nanocrystals and silica aerogels. Carbohydr. Polym. 2022, 298, 120116. [Google Scholar] [CrossRef] [PubMed]
- Karim, F.E.; Islam, M.R.; Ahmed, R.; Siddique, A.B.; Begum, H.A. Extraction and characterization of a newly developed cellulose enriched sustainable natural fiber from the epidermis of Mikaniamicrantha. Heliyon 2023, 9, e19360. [Google Scholar] [CrossRef]
- Surek, M.; Cobre, A.D.F.; Fachi, M.M.; Santos, T.G.; Pontarolo, R.; Crisma, A.R.; Felipe, K.B.; Souza, W.M.D. Propolis authentication of stingless bees by mid-infrared spectroscopy and chemometric analysis. LWT 2022, 161, 113370. [Google Scholar] [CrossRef]
- Meda, R.S.; Jain, S.; Singh, S.; Verma, C.; Nandi, U.; Maji, P.K. Novel Lagenariasiceraria peel waste based cellulose nanocrystals: Isolation and rationalizing H-bonding interactions. Ind. Crop. Prod. 2022, 186, 115197. [Google Scholar] [CrossRef]
- Moţ, A.C.; Silaghi-Dumitrescu, R.; Sârbu, C. Rapid and effective evaluation of the antioxidant capacity of propolis extracts using DPPH bleaching kinetic profiles, FT-IR and UV–vis spectroscopic data. J. Food Compos. Anal. 2011, 24, 516–522. [Google Scholar] [CrossRef]
- Laaroussi, H.; Ferreira-Santos, P.; Genisheva, Z.; Bakour, M.; Ousaaid, D.; Teixeira, J.A.; Lyoussi, B. Unraveling the chemical composition, antioxidant, α-amylase and α-glucosidase inhibition of Moroccan propolis. Food Biosci. 2021, 42, 101160. [Google Scholar] [CrossRef]
- Frone, A.N.; Panaitescu, D.M.; Nicolae, C.A.; Gabor, A.R.; Trusca, R.; Casarica, A.; Stanescu, P.O.; Baciu, D.D.; Salageanu, A. Bacterial cellulose sponges obtained with green cross-linkers for tissue engineering. Mater. Sci. Eng. C 2020, 110, 110740. [Google Scholar] [CrossRef]
- Khoshnevisan, K.; Maleki, H.; Samadian, H.; Doostan, M.; Khorramizadeh, M.R. Antibacterial and antioxidant assessment of cellulose acetate/polycaprolactonenanofibrous mats impregnated with propolis. Int. J. Biol. Macromol. 2019, 140, 1260–1268. [Google Scholar] [CrossRef] [PubMed]
- Pant, K.; Thakur, M.; Chopra, H.K.; Nanda, V. Encapsulated bee propolis powder: Drying process optimization and physicochemical characterization. LWT 2022, 155, 112956. [Google Scholar] [CrossRef]
- Mutuk, T.; Gürbüz, M. Surface modification of Ni–Ti stents by biodegradable binary PVA/propoliselectrospunnano fibers. Arab. J. Sci. Eng. 2023, 48, 3391–3402. [Google Scholar] [CrossRef]
- Da Silva Barud, B.; de AraújoJúnior, A.M.; Saska, S.; Mestieri, L.B.; Campos, J.A.D.B.; de Freitas, R.M.; Ferreira, N.U.; Nascimento, A.P.; Miguel, F.G.; Vaz, M.M.; et al. Antimicrobial Brazilian propolis (EPP-AF) containing biocellulose membranes as promising biomaterial for skin wound healing. eCAM 2013, 2013, 703024. [Google Scholar] [CrossRef]
- Roman, M.; Winter, W.T. Effect of sulfate groups from sulfuric acid hydrolysis on the thermal degradation behavior of bacterial cellulose. Biomacromolecules 2004, 5, 1671–1677. [Google Scholar] [CrossRef]
- D’Acierno, F.; Hamad, W.Y.; Michal, C.A.; MacLachlan, M.J. Thermal Degradation of Cellulose Filaments and Nanocrystals. Biomacromolecules 2020, 21, 3374–3386. [Google Scholar] [CrossRef]
- Kim, J.; Bang, J.; Kim, Y.; Kim, J.; Hwang, S.; Yeo, H.; Choi, I.; Kwak, H.W. Eco-friendly alkaline lignin/cellulose nanofiber drying system for efficient redispersion behavior. Carbohydr. Polym. 2022, 282, 119122. [Google Scholar] [CrossRef]
- Panaitescu, D.M.; Frone, A.N.; Chiulan, I.; Casarica, A.; Nicolae, C.A.; Ghiurea, M.; Trusca, R.; Damian, C.M. Structural and morphological characterization of bacterial cellulose nano-reinforcements prepared by mechanical route. Mater. Des. 2016, 110, 790–801. [Google Scholar] [CrossRef]
- Suriyatem, R.; Auras, R.A.; Rachtanapun, C.; Rachtanapun, P. Biodegradable rice starch/carboxymethyl chitosan films with added propolis extract for potential use as active food packaging. Polymers 2018, 10, 954. [Google Scholar] [CrossRef]
- Borsoi, C.; Zimmernnam, M.V.G.; Zattera, A.J.; Santana, R.M.C.; Ferreira, C.A. Thermal degradation behavior of cellulose nanofibers and nanowhiskers. J. Therm. Anal.Calorim. 2016, 126, 1867–1878. [Google Scholar] [CrossRef]
- Hu, R.Z.; Zhang, Z.F.; Yu, B.Q.; Wang, J.; Yao, X.H.; Chen, T.; Zhao, W.G.; Zhang, D.Y. Natural phenolics and flavonoids modified the hierarchical cellular cellulose sponges for efficient water disinfection. Carbohydr. Polym. 2022, 296, 119962. [Google Scholar] [CrossRef]
- Huang, Y.; Wang, J.; Yang, F.; Shao, Y.; Zhang, X.; Dai, K. Modification and evaluation of micro-nano structured porous bacterial cellulose scaffold for bone tissue engineering. Mater. Sci. Eng. C 2017, 75, 1034–1041. [Google Scholar] [CrossRef]
- Cherian, R.M.; Varghese, R.T.; Antony, T.; Malhotra, A.; Kargarzadeh, H.; Chauhan, S.R.; Chauhan, A.; Chirayil, C.J.; Thomas, S. Non-cytotoxic, highly functionalized cellulose nanocrystals with high crystallinity and thermal stability derived from a novel agromass of Elettaria cardamomum, using a soft and benign mild oxalic acid hydrolysis. Int. J. Biol. Macromol. 2023, 253 Pt 1, 126571. [Google Scholar] [CrossRef]
- Bhuyan, D.J.; Alsherbiny, M.A.; Low, M.N.; Zhou, X.; Kaur, K.; Li, G.; Li, C.G. Broad-spectrum pharmacological activity of Australian propolis and metabolomic-driven identification of marker metabolites of propolis samples from three continents. Food Funct. 2021, 12, 2498–2519. [Google Scholar] [CrossRef]
- Takaisi-Kikuni, N.B.; Schilcher, H. Electron microscopic and microcalorimetric investigations of the possible mechanism of the antibacterial action of a defined propolis provenance. Planta Medica 1994, 60, 222–227. [Google Scholar] [CrossRef]
- Duca, A.; Sturza, A.; Moacă, E.-A.; Negrea, M.; Lalescu, V.-D.; Lungeanu, D.; Dehelean, C.-A.; Muntean, D.-M.; Alexa, E. Identification of Resveratrol as Bioactive Compound of Propolis from Western Romania and Characterization of Phenolic Profile and Antioxidant Activity of Ethanolic Extracts. Molecules 2019, 24, 3368. [Google Scholar] [CrossRef] [PubMed]
- Scott, C.P.; Higham, P.A. Antibiotic bone cement for the treatment of Pseudomonas aeruginosa in joint arthroplasty: Comparison of tobramycin and gentamicin-loaded cements. J. Biomed. Mater. Res. B Appl. Biomater. 2003, 64, 94–98. [Google Scholar] [CrossRef] [PubMed]
- Palombo, E.A.; Semple, S.J. Antibacterial activity of Australian plant extracts against methicillin-resistant Staphylococcus aureus (MRSA) and vancomycin-resistant enterococci (VRE). J. Basic Microbiol. 2002, 42, 444–448. [Google Scholar] [CrossRef] [PubMed]
- Rahman, M.M.; Richardson, A.; Sofian-Azirun, M. Antibacterial activity of propolis and honey against Staphylococcus aureus and Escherichia coli. Afr. J. Microbiol. Res. 2010, 4, 1872–1878. [Google Scholar]
- Lin, J.; Opoku, A.R.; Geheeb-Keller, M.; Hutchings, A.D.; Terblanche, S.E.; Jäger, A.K.; van Staden, J. Preliminary screening of some traditional zulu medicinal plants for anti-inflammatory and anti-microbial activities. J. Ethnopharmacol. 1999, 68, 267–274. [Google Scholar] [CrossRef] [PubMed]
- Mortazavi Moghadam, F.A.; Khoshkalampour, A.; Mortazavi Moghadam, F.A.; Pourvatan Doust, S.; Naeijian, F.; Ghorbani, M. Preparation and physicochemical evaluation of casein/basil seed gum film integrated with guar gum/gelatin based nanogel containing lemon peel essential oil for active food packaging application. Int. J. Biol. Macromol. 2023, 224, 786–796. [Google Scholar] [CrossRef]
- Grecka, K.; Kuś, P.M.; Okińczyc, P.; Worobo, R.W.; Walkusz, J.; Szweda, P. The Anti-Staphylococcal Potential of Ethanolic Polish Propolis Extracts. Molecules 2019, 24, 1732. [Google Scholar] [CrossRef]
- Mirzoeva, O.K.; Grishanin, R.N.; Calder, P.C. Antimicrobial action of propolis and some of its components: The effects on growth, membrane potential and motility of bacteria. Microbiol. Res. 1997, 152, 239–246. [Google Scholar] [CrossRef] [PubMed]
- Saeed, A.; Donkor, E.S.; Arhin, R.E.; Tetteh-Quarcoo, P.B.; Attah, S.K.; Kabotso, D.E.K.; Kotey, F.C.N.; Dayie, N.T.K.D. In vitro antimicrobial activity of crude propolis extracts and fractions. FEMS Microbes 2023, 4, xtad010. [Google Scholar] [CrossRef] [PubMed]
- Pachori, P.; Gothalwal, R.; Gandhi, P. Emergence of antibiotic resistance Pseudomonas aeruginosa in intensive care unit; a critical review. Genes Dis. 2019, 6, 109–119. [Google Scholar] [CrossRef] [PubMed]
- Kasmiyati, S.; Kristiani, E.B.E.; Herawati, M.M.; Sukmana, A.B.A. Antibacterial Activity and Flavonoids Content of Artemisia cina Berg. ex Poljakov Ethyl Acetate Extracts. Biosaintifika 2021, 13, 106–112. [Google Scholar] [CrossRef]
- Makarewicz, M.; Drożdż, I.; Tarko, T.; Duda-Chodak, A. The Interactions between Polyphenols and Microorganisms, Especially Gut Microbiota. Antioxidants 2021, 10, 188. [Google Scholar] [CrossRef]

| Sample | mNC suspension (g) | mNC (g) | mPE (g) | mpropolis(g) |
|---|---|---|---|---|
| NC/PE 4/0 | 50 | 0.750 | - | - |
| NC/PE 4/2 | 50 | 0.750 | 1.875 | 0.375 |
| NC/PE 4/3 | 50 | 0.750 | 2.813 | 0.563 |
| NC/PE 4/4 | 50 | 0.750 | 3.750 | 0.750 |
| Sample | T5% (°C) | Ton (°C) | Tmax (°C) | R600°C (%) |
|---|---|---|---|---|
| NC/PE 4/0 | 225.0 | 323.1 | 344.6 | 0.068 |
| NC/PE 4/2 | 203.9 | 326.2 | 353.9 | 0.147 |
| NC/PE 4/3 | 193.3 | 322.1 | 352.0 | 0.150 |
| NC/PE 4/4 | 191.5 | 319.1 | 350.6 | 0.159 |
| Samples | Strain | Growth Inhibition Zones [mm] |
|---|---|---|
| NC/PE 4/0 | Staphylococcus aureus ATCC 29213 | no inhibition zone |
| NC/PE 4/2 | Staphylococcus aureus ATCC 29213 | 2.5 ± 0.3 |
| NC/PE 4/3 | Staphylococcus aureus ATCC 29213 | 3.0 ± 0.1 |
| NC/PE 4/4 | Staphylococcus aureus ATCC 29213 | 2.1 ± 0.3 |
| NC/PE 4/0 | MRSA clinical isolate | no inhibition zone |
| NC/PE 4/2 | MRSA clinical isolate | 2.0 ± 0.4 |
| NC/PE 4/3 | MRSA clinical isolate | 3.0 ± 0.3 |
| NC/PE 4/4 | MRSA clinical isolate | 1.5 ± 0.3 |
| NC/PE 4/0 | Pseudomonas aeruginosa ATCC 27853 | no inhibition zone |
| NC/PE 4/2 | Pseudomonas aeruginosa ATCC 27853 | 32.0 ± 0.7 * |
| NC/PE 4/3 | Pseudomonas aeruginosa ATCC 27853 | 35.0 ± 0.0 * |
| NC/PE 4/4 | Pseudomonas aeruginosa ATCC 27853 | 34.5 ± 0.7 * |
Disclaimer/Publisher’s Note: The statements, opinions and data contained in all publications are solely those of the individual author(s) and contributor(s) and not of MDPI and/or the editor(s). MDPI and/or the editor(s) disclaim responsibility for any injury to people or property resulting from any ideas, methods, instructions or products referred to in the content. |
© 2023 by the authors. Licensee MDPI, Basel, Switzerland. This article is an open access article distributed under the terms and conditions of the Creative Commons Attribution (CC BY) license (https://creativecommons.org/licenses/by/4.0/).
Share and Cite
Oprică, G.M.; Panaitescu, D.M.; Lixandru, B.E.; Uşurelu, C.D.; Gabor, A.R.; Nicolae, C.-A.; Fierascu, R.C.; Frone, A.N. Plant-Derived Nanocellulose with Antibacterial Activity for Wound Healing Dressing. Pharmaceutics 2023, 15, 2672. https://doi.org/10.3390/pharmaceutics15122672
Oprică GM, Panaitescu DM, Lixandru BE, Uşurelu CD, Gabor AR, Nicolae C-A, Fierascu RC, Frone AN. Plant-Derived Nanocellulose with Antibacterial Activity for Wound Healing Dressing. Pharmaceutics. 2023; 15(12):2672. https://doi.org/10.3390/pharmaceutics15122672
Chicago/Turabian StyleOprică, Gabriela Mădălina, Denis Mihaela Panaitescu, Brînduşa Elena Lixandru, Catalina Diana Uşurelu, Augusta Raluca Gabor, Cristian-Andi Nicolae, Radu Claudiu Fierascu, and Adriana Nicoleta Frone. 2023. "Plant-Derived Nanocellulose with Antibacterial Activity for Wound Healing Dressing" Pharmaceutics 15, no. 12: 2672. https://doi.org/10.3390/pharmaceutics15122672
APA StyleOprică, G. M., Panaitescu, D. M., Lixandru, B. E., Uşurelu, C. D., Gabor, A. R., Nicolae, C.-A., Fierascu, R. C., & Frone, A. N. (2023). Plant-Derived Nanocellulose with Antibacterial Activity for Wound Healing Dressing. Pharmaceutics, 15(12), 2672. https://doi.org/10.3390/pharmaceutics15122672

